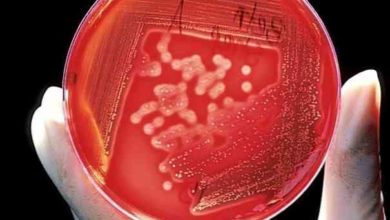
Photo of Gonore bebeğe de bulaşabiliyor

gonore
- Oca- 2022 -19 OcakGÜNDEM

Gonore bebeğe de bulaşabiliyor
Dünya çapında en sık karşılaşılan cinsel yolla bulaşan hastalıklardan biri olan ve halk arasında bel soğukluğu olarak bilinen gonore hakkında…
Devamını Oku » - Tem- 2021 -2 TemmuzERKEK

Bel soğukluğundan korunma yolları
Cinsel yolla bulaşan bel soğukluğu, çok eşli ve ilişki esnasında korunmayan kişilerde görülebiliyor. Hem erkeklerde hem de kadınlarda kendini gösterebilen…
Devamını Oku »